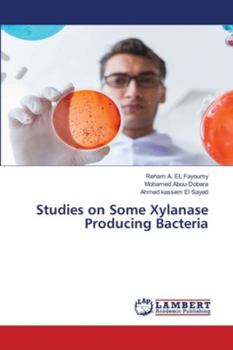
Paperback Studies on Some Xylanase Producing Bacteria Book

Studies on Some Xylanase Producing Bacteria
Xylanase enzymes hydrolyze xylan substrates and play a major role in industries. Xylanases are most distributed enzymes in bacteria, fungi and plants. For commercial applications, xylanases should ideally be produced quickly and in large quantities from simple and inexpensive substrates. Natural xylan sources such as agricultural and forestry wastes, paper industry wastes and various fruit wastes are potential raw materials for xylanase production.
Format:Paperback
Language:English
ISBN:6200250553
ISBN13:9786200250551
Release Date:May 2020
Publisher:LAP Lambert Academic Publishing
Length:168 Pages
Weight:0.56 lbs.
Dimensions:0.4" x 6.0" x 9.0"
Customer Reviews
0 rating